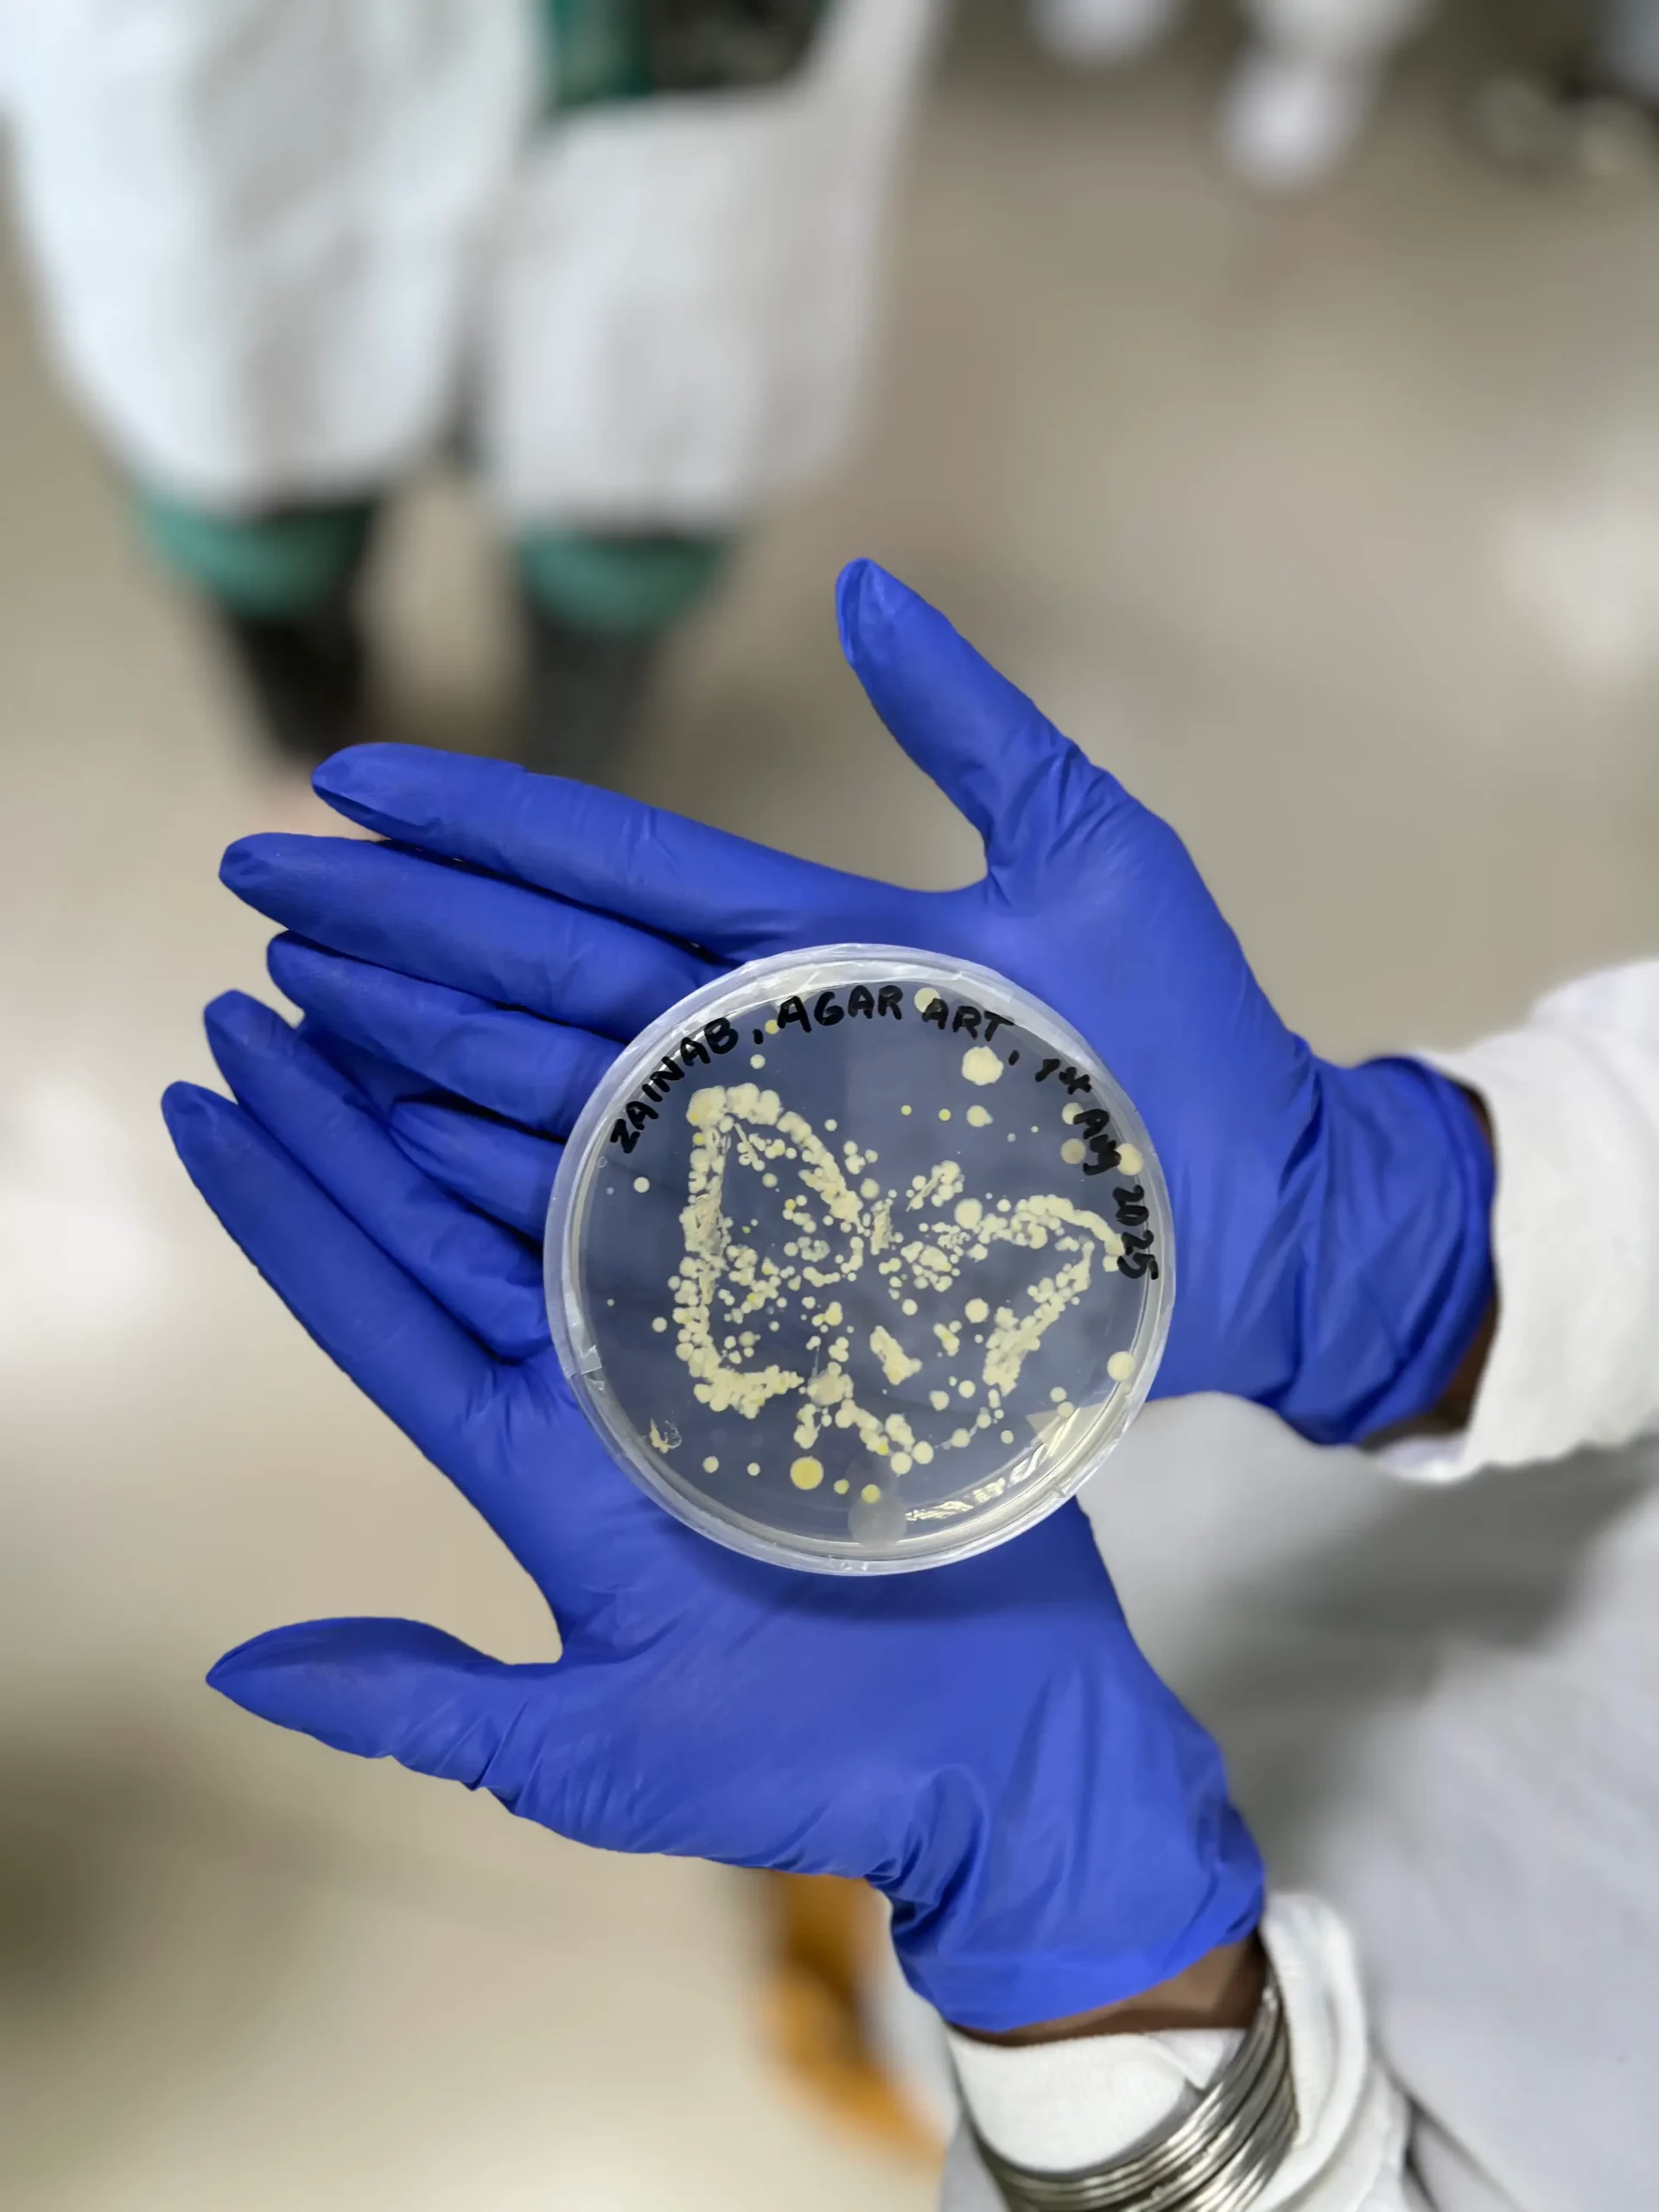

Workshops & Sprints
The Summer Elective Program includes a series of carefully designed workshops and sprints that provide students with hands-on experience in advanced research techniques. These sessions, led by experts, are integral to the program, focusing on equipping participants with the practical skills required to excel in contemporary research environments.
Throughout the 8 weeks, students engaged in multiple sprints and workshops including Zine Making, Terrarium Building, Agar Art, Design Thinking, and gene expression analysis, alongside sessions covering foundational topics such as data analysis, laboratory safety, and essential research methodologies. Meanwhile, sprints were intensive, short-duration sessions focused on specific areas of research, such as space biology and applications of deep learning in biomedical science. These activities were structured to allow students to apply their learning in practical settings, encouraging both individual and collaborative problem-solving.
By participating in these workshops and sprints, students were exposed to the latest advancements in various research fields and gained a deeper understanding of how interdisciplinary research is conducted. These sessions also fostered critical thinking and enhanced students’ ability to approach complex scientific problems with practical, real-world solutions.